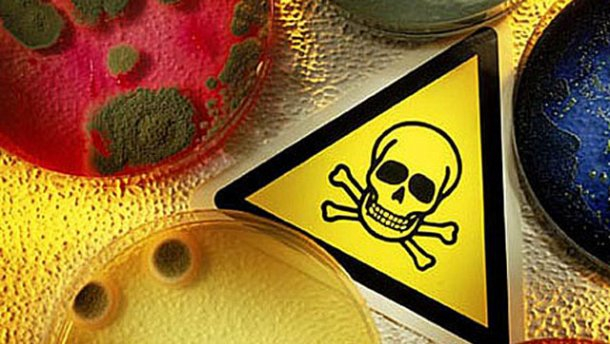

В січні 2019 року в Івано-Франківській області зареєстровано перший випадок лептоспірозу.
Причиною захворювання стало вживання немитого яблука, яке ймовірно було забруднене екскрементами миші, інформує Фіртка.
За даними лабораторії особливо небезпечних інфекцій у 2018 році встановлено, що майже 5,0% мишей, які були відловлені в населених пунктах області та досліджені в лабораторії, були інфіковані лептоспірами.
"Мишевидні гризуни є переносниками до 40 різних інфекцій. Доведено, що з їх вини загинуло більше людей, ніж при всіх війнах і революціях, які відбулися на Землі. Мишовидні гризуни приймають безпосередню участь у поширенні багатьох особливо небезпечних інфекцій для людей та тварин – це чума, сказ, лептоспіроз, лістеріоз, Ку- гарячка, рикетсіози", - пояснюють спеціалісти.
В 2018 році в на Прикарпатті зареєстровано 31 випадок лептоспірозу, три з яких завершились летально.
В переважній більшості захворювання протікало з важкими ускладненнями та лікуванням в реанімаційних відділеннях.
Згідно проведених епідеміологічних розслідувань встановлено, що основним джерелом інфекції (80,7%) були миші. В чотири рази частіше хворіли чоловіки, ніж жінки. В переважній більшості хворіли на лептоспіроз пенсіонери та безробітні (87,1% випадків).
Вперше в області зареєстровано захворювання на лептоспіроз в дитини семи років: спровокувала захворювання немита грушка.
Основний шлях проникнення лептоспір в організм людини через ушкоджену шкіру та слизові оболонки.
Довідка:
Лептоспіроз – це гостре інфекційне захворювання людей і тварин, що викликається збудником лептоспір, і характеризується ураженням печінки, нирок, м'язів і супроводжується постійною лихоманкою.
З моменту зараження до початку хвороби проходить від 6 до 20 днів. Захворювання починається переважно гостро, підвищується температура тіла до 39-40 С, хворі скаржаться на сильний головний біль, слабкість, біль у м'язах, особливо литкових.
Основними носіями збудника лептоспірозу в природних умовах є щури, польові миші, землерийки, їжаки.
Зараження зазвичай відбувається в воді через пошкоджену шкіру або слизові оболонки. Водночас, від людини до людини ця інфекція не передається.
























